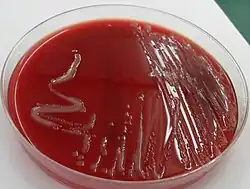

Dwoinka zapalenia opon mózgowo-rdzeniowych
![]() | |
| Systematyka | |
| Domena | |
|---|---|
| Typ | |
| Klasa |
betaproteobakterie |
| Rząd | |
| Rodzina | |
| Rodzaj | |
| Gatunek |
Dwoinka zapalenia opon mózgowo-rdzeniowych |
| Nazwa systematyczna | |
| Neisseria meningitidis Albrecht & Ghon 1901 | |
Dwoinka zapalenia opon mózgowo-rdzeniowych, meningokok (Neisseria meningitidis) – gatunek Gram-ujemnych bakterii wywołujący zapalenie opon mózgowo-rdzeniowych oraz posocznicę meningokokową.
Budowa i właściwości
Neisseria meningitidis to Gram-ujemne ziarenkowce wielkości 0,6–1,0 μm złączone ze sobą bokami, tworząc pary (dwoinki)[1][2]. Budowa Neisseria meningitidis nie odbiega od budowy innych bakterii Gram-ujemnych – komórka jest otoczona błoną zewnętrzną złożoną z lipidów, białek błony zewnętrznej (OMP) i lipopolisacharydów (LPS). Lipopolisacharyd posiada krótsze łańcuchy niż typowo i jest nazywany lipooligosacharydem (LOS)[3]. Na podstawie budowy otoczki wyróżnia się 13 grup serologicznych: A, B, C, D, X, Y, Z, W135, 29E, H, I, K i L, przy czym za 90% zakażeń odpowiadają serotypy A, B, C, Y i W135. Możliwe są szczepy bezotoczkowe i te bardzo rzadko wywołują zakażenia[3]. Choć większość ziarenkowców jest oksydazoujemna, to Neisseria meningitidis jest bakterią oksydazododatnią[2]. Większość tych bakterii wytwarza katalazę[1]. Ponadto cechują się zdolnością do utleniania maltozy i glukozy[1].
Czynniki determinujące zjadliwość
Głównym czynnikiem wirulencji (zjadliwości) Neisseria meningitidis jest otoczka wielocukrowa chroniąca przed fagocytozą[4][5]. Lipooligosacharyd (LOS) składa się z lipidu A i oligosacharydu rdzeniowego, a pozbawiony jest antygenu O obecnego w większości lipopolisacharydów bakterii Gram-ujemnych. Lipid A pełni funkcję endotoksyny. W trakcie szybkiego wzrostu Neisseria meningitidis uwalnia formowane z błony zewnętrznej pęcherzyki zawierające lipooligosacharyd oraz białka powierzchniowe, co chroni bakterie przed przyłączeniem swoistych przeciwciał, ale także jest powodem znacznej toksyczności[6]. Uwalnianie lipooligosacharydu jest elementem przyczyniającym się do rozwoju wstrząsu septycznego[7].
Fimbrie Neisseria meningitidis wykazują zdolność do adhezji do nieurzęsionych komórek nabłonkowych śluzówki jamy nosowej i gardła[8][2]. Fimbrie płciowe umożliwiają wymianę materiału genetycznego[8]. Białka porynowe PorA i PorB służą do pobierania substancji odżywczych i usuwania produktów przemiany materii na zewnątrz[6]. Również błonowe białka Opa pełnią rolę w adhezji bakterii do komórek nabłonka[6][5].
Proteaza IgA rozcina immunoglobuliny A w miejscu zawiasowym[2], bakteria niszcząc swoiste immunoglobuliny zwiększa swoje szanse na kolonizację błony śluzowej[5]. Istotną cechą Neisseria meningitidis jest zdolność do pobierania za pomocą białek powierzchniowych jonów żelaza z ludzkiej transferyny[5].
Epidemiologia
Jedynym rezerwuarem bakterii jest człowiek chory lub bezobjawowy nosiciel. Dwoinki przenoszą się drogą kropelkową lub przez bezpośredni kontakt z człowieka na człowieka[9][10]. Zakażenia Neisseria meningitidis mogą występować sporadycznie, endemicznie lub epidemicznie. Epidemie zwykle są związane z grupami A, C i W135, najczęściej pojawiają się w środowiskach zamkniętych takich jak szkoły, akademiki, domy opieki, koszary czy więzienia[3].
Co roku na świecie rozpoznaje się około 500 000–1 200 000 przypadków inwazyjnej choroby meningokowej i około 50 000–130 000 zgonów. W Europie i Ameryce Północnej roczna zapadalność jest szacowana od 0,3 do 3 przypadków na 100 000, a znacznie wyższa jest w Afryce Subsaharyjskiej, gdzie zapadalność waha się od 10 do 1000 przypadków na 100 000[11]. Obserwuje się dwa szczyty zapadalności na Neisseria meningitidis. Pierwszy i największy pik zapalności dotyczy dzieci około 5 roku życia, szczególnie dzieci do 1 roku życia, co jest związane z niedojrzałością układu immunologicznego. W tej grupie najczęściej zakażenia są spowodowane grupą B, a w mniejszym stopniu C. Kolejny szczyt zapadalności pojawia się u młodzieży i młodych dorosłych (15–24. rok życia), co jest związane z nosicielstwem i stylem życia. W tej grupie wiekowej dominują meningokoki serogrupy C[12][11].
Chorobotwórczość

Zakażenie Neisseria meningitidis (inwazyjna choroba meningokowa) może przebiegać jako sepsa, która u części chorych ma przebieg piorunujący z obecnym wstrząsem septycznym i zespołem wykrzepiania wewnątrznaczyniowego (DIC), oraz jako zapalenie opon mózgowo-rdzeniowych (ZOMR). U części chorych jednocześnie rozwija się sepsa i zapalenie opon mózgowo-rdzeniowych[12].
Bakterie przenoszą się drogą kropelkową lub przez bezpośredni kontakt z człowieka na człowieka. Bakterie przy pomocy białek błony zewnętrznej i pili kolonizują jamę nosowo-gardłową. W wyniku ich przylegania i transportu bakterii w wakuolach nabłonka Neisseria meningitidis przedostaje się do krwiobiegu. Okres wylęgania wynosi od 2 do 10 dni, najczęściej 3–4 dni[9].
Sepsa meningokokowa
Około 5–20% przypadków inwazyjnej choroby meningokokowej przebiega jako sepsa o wysokiej śmiertelności sięgającej 20–80%[13]. Choroba początkowo może przebiegać jako nieswoista choroba gorączkowa, która może prowadzić do bardzo szybkiego pogorszenia stanu chorego i nierzadko do zgonu w ciągu 12–24 godzin od początku choroby[14].
Początkowo pojawiają niecharakterystyczne objawy jak dreszcze, tachykardia, zwiększenie liczby oddechów, bóle mięśniowe i stawowe, a także bóle brzucha. Następnie pojawia się spadek ciśnienia tętniczego, bladość, oziębienie kończyn, skąpomocz i sinica[9]. Typowym i wczesnym objawem jest pojawienie się wybroczyn. Początkowo są one pojedyncze, wielkości 1–2 mm, charakterystyczną ich cechą jest nieblednięcie pod wpływem ucisku („test szklankowy” – uciśnięcie wybroczyn bokiem szklanki). Wybroczyny są przede wszystkim zlokalizowane w obrębie dystalnych części kończyn, ponadto występują w obrębie tułowia, spojówek, śluzówek jamy ustnej i podniebienia. W miarę upływu czasu wybroczyn jest więcej, stają się one większe i mogą ulegać zlewaniu, tworząc duże, kilkucentymetrowe podbiegnięcia krwawe o ostro odgraniczonym, nieregularnym brzegu[9]. Jednak wybroczyny nie są swoistym objawem dla inwazyjnej choroby meningokokowej, ocenia się, że około 2–11% przypadków wybroczyn u dzieci z gorączką jest związanych z inwazyjną chorobą meningokokową, a większość z nich jest spowodowanych infekcjami wirusowymi, przede wszystkim adenowirusami[15]. W rozwiniętym zespole wykrzepiania wewnątrznaczyniowego dochodzi do krwawień z dziąseł, śluzówek, miejsc wkłuć dożylnych i przewodu pokarmowego[9], a także powikłań zakrzepowo-zatorowych w postaci martwicy skóry, zatorowości płucnej oraz niedokrwienia kończyn, nierzadko kończącego się ich utratą[13]. Krwotok do nadnerczy może być powodem ostrej niewydolności nadnerczy (zespół Waterhouse’a-Friderichsena), co klinicznie objawia się jako nagły spadek ciśnienia tętniczego[9]. W zaawansowanej sepsie dochodzi do niewydolności wielonarządowej z głębokimi zaburzeniami świadomości, niewydolności serca i niewydolności nerek. Choroba może prowadzić do zgonu[13].
Meningokokowe zapalenie opon mózgowo-rdzeniowych
U połowy chorych inwazyjna choroba meningokokowa przebiega jako zapalenie opon mózgowo-rdzeniowych[13]. Choroba początkowo może objawiać się gorączką, silnym i narastającym bólem głowy, sztywnością karku i innymi objawami oponowymi, nudnościami, wymiotami, światłowstrętem, napadem drgawkowym oraz zaburzeniami świadomości[13][16]. U niemowląt i małych dzieci objawy mogą być bardziej niespecyficzne, a choroba może objawiać się utratą apetytu, wymiotami, biegunką, rozdrażnieniem, nadmierną płaczliwością, nadmierną sennością i brakiem zainteresowania otoczeniem. W późniejszym stadium może pojawić się powiększenie i napięcie ciemiączka[16]. Śmiertelność w tej postaci klinicznej jest oceniana na 5–10% przypadków[13].
Meningokokowe zapalenie płuc
Około 5–15% przypadków inwazyjnej choroby meningokokowej może przebiegać jako zapalenie płuc. Postać jest zwykle związana z serogrupą Y[13]. Postać często jest poprzedzona infekcją górnych dróg oddechowych. Choroba objawia się gorączką, dreszczami, kaszlem, dusznością, bólem w klatce piersiowej oraz objawami osłuchowymi[17].
Inne postacie zakażeń meningokowych
Rzadszymi postaciami zakażenia Neisseria meningitidis są zapalenie stawów, zapalenie spojówek, zapalenie osierdzia, zapalenie mięśnia sercowego, pierwotne zapalenie otrzewnej oraz zapalenie kości i szpiku[14].
Przewlekła bakteriemia
Jest to rzadka postać zakażenia polegająca na nawracających epizodach gorączki, wysypki, bólów stawów i bólów głowy związanych z okresową bakteriemią ustępującą bez leczenia[14]. Choroba może trwać miesiącami i samoistnie ustąpić, jednak również może przejść w bardziej poważną postać, jak zapalenie opon mózgowo-rdzeniowych[13].
Rozpoznanie
Rozpoznanie choroby jest stawiane na podstawie obrazu klinicznego choroby oraz badań laboratoryjnych[13].
Badania laboratoryjne
W badaniach laboratoryjnych obserwuje się leukocytozę z odmłodzeniem obrazu w rozmazie, podwyższone stężenie wykładników stanu zapalnego (CRP, prokalcytonina). W przypadku rozwinięcia zespołu wykrzepiania wewnątrznaczyniowego może dojść do spadku liczby płytek (trombocytopenia), zwiększenia stężenia D-dimerów, produktów degradacji fibrynogenu, obniżenia stężenia czynników krzepnięcia, wydłużenia czasu protrobinowego (PT) oraz czasu kaolinowo-kefalinowego (APTT). W przypadku wstrząsu septycznego i niewydolności wielonarządowej mogą być obecne kliniczne i laboratoryjne cechy uszkodzenia narządów. W badaniach laboratoryjnych stwierdzana jest kwasica mleczanowa, hipoksemia, hipokapnia, podwyższone stężenie kreatyniny, zwiększona aktywność aminotransferaz, zwiększone stężenie bilirubiny i zwiększone INR[16].
W przypadku zapalenia opon mózgowo-rdzeniowych konieczne jest badanie ogólne i mikrobiologiczne płynu mózgowo-rdzeniowego pobranego podczas nakłucia lędźwiowego. W badaniu ogólnym płynu mózgowo-rdzeniowego obserwuje się zmiany typowe dla ropnego zapalenia opon mózgowo-rdzeniowych: płyn jest mętny, cytoza waha się od kilkuset do kilku tysięcy komórek w milimetrze sześciennym, w rozmazie dominują granulocyty obojętnochłonne, stężenie białka jest podwyższone, stężenie glukozy jest obniżone[16].
Badania mikrobiologiczne
W celu ustalenia czynnika chorobotwórczego „złotym standardem” jest hodowla drobnoustroju z materiału biologicznego pobranego od chorego. Konieczne jest wykonanie posiewów krwi, a w przypadku podejrzenia zapalenia opon mózgowo-rdzeniowych posiew płynu mózgowo-rdzeniowego. W przypadku występowania typowych wykwitów o charakterze naczyniowym do posiewu mogą być pobierane wymazy z takich zmian, które pobierane są metodą biopsji lub nacięcia zmiany z pobraniem wymazu z jej wnętrza[16].
Neisseria meningitidis wymaga specjalnych wzbogaconych podłoży[2]. Bakteria jest wrażliwa na wysychanie, dlatego konieczne jest jej wysianie na wilgotne podłoże[18]. W hodowli tych bakterii stosuje się podłoża nieselektywne, takie jak agar czekoladowy, oraz podłoża selektywne, takie jak podłoże Thayera-Martina, hamujące wzrost zanieczyszczających próbkę innych bakterii[19][18]. Rutynowo oznacza się wrażliwość bakterii na antybiotyki (antybiogram)[20]. Wstępna identyfikacja Neisseria meningitidis polega na stwierdzeniu oksydazododatnich Gram-ujemnych dwoinek wzrastających na agarze czekoladowym i podłożu wybiórczym, ale ostateczna identyfikacja wymaga zastosowania testów biochemicznych[19].
Testy do szybkiej diagnostyki oparte na aglutynacji antygenów otoczkowych na lateksie (odczyn lateksowy), pomimo niższej swoistości, mogą być przydatne, ponieważ umożliwiają szybkie otrzymanie wyniku dodatniego, oraz, dzięki wykrywaniu antygenów również ze zniszczonych bakterii, umożliwiają rozpoznanie patogenu pomimo zastosowania antybiotyków[19][16]. Wykrywanie materiału genetycznego bakterii za pomocą PCR umożliwia rozpoznanie Neisseria meningitidis[21][14].
Grupy serologiczne mogą być oznaczane metodą aglutynacji szkiełkowej z użyciem odpowiedniego zestawu surowic. W pełnym typowaniu serologicznym stosuje się test ELISA lub immunoblotting[22].
Leczenie

W przypadku postawienia podejrzenia lub rozpoznania inwazyjnej choroby meningokowej konieczne jest niezwłoczne wdrożenie dożylnej antybiotykoterapii. W porównaniu do innych gatunków bakterii Neisseria meningitidis jest wrażliwa na większość leków przeciwbakteryjnych. Zatem wysoka śmiertelność jest efektem wysokiej zjadliwości bakterii, a nie jej oporności na leczenie[21].
W leczeniu inwazyjnej choroby meningokokowej stosuje się penicylinę krystaliczną (penicylina G, benzylopenicylina) w dawce dobowej 20–24 mln IU lub cefalosporyny III generacji takie jak ceftriakson w dawce dobowej 4 g czy cefotaksym w dawce dobowej 6–8 g. W przypadku braku rozpoznania czynnika etiologicznego w leczeniu empirycznym zapalenia opon mózgowo-rdzeniowych stosuje się cefalosporyny III generacji w skojarzeniu z wankomycyną lub ampicyliną (w zależności od wieku chorego i czynników ryzyka)[21].
Profilaktyka poekspozycyjna
W przypadku rozpoznania zakażenia meningokokowego zaleca się profilaktykę antybiotykową u osób, które w ciągu ostatnich 7 dni miały bliski kontakt z chorymi. W profilaktyce stosuje się ceftriakson, ryfampicynę lub cyprofloksacynę[23].
Szczepienia ochronne

W profilaktyce zakażenia meningokokami stosuje się szczepienia ochronne. Dostępne są szczepionki skoniugowane monowalentne przeciw grupie C, skoniugowane czterowalentne przeciw grupie A, C, W135 i Y, polisacharydowe przeciw grupie A i C oraz rekombinowana monowalentna przeciw grupie B[24].
Szczepienie przeciw Neisseria meningitidis jest szczepieniem zalecanym u[25]:
- niemowląt i dzieci, szczególnie uczęszczających do żłobka, przedszkola albo szkoły lub gdy ich starsze rodzeństwo uczęszcza do przedszkola albo szkoły,
- młodzieży i młodych dorosłych, szczególnie mieszkających w internacie, akademiku lub koszarach,
- osób z anatomicznym lub czynnościowym brakiem śledziony,
- osób z niedoborem odpowiedzi humoralnej, szczególnie z niedoborami końcowych składowych układu dopełniacza lub properdyny[24],
- personelu medycznego narażonego na kontakt z osobami chorymi,
- podróżujących na tereny endemicznego i epidemicznego występowania zakażeń Neisseria meningitidis.
W zależności od wieku osoby szczepionej mogą być podawane preparaty[26]:
- szczepionka rekombinowana monowalentna przeciw serogrupie B od ukończenia 2 miesiąca życia (Bexsero),
- szczepionka skoniugowana monowalentna przeciw serogrupie C od ukończenia 2 miesiąca życia (Meningitec, NeisVac-C),
- szczepionka skoniugowana czterowalentna przeciw serogrupom A, C, W-135, Y od 12 miesiąca życia (Menveo, Nimenrix),
- szczepionka polisacharydowa przeciw serogrupom A i C dzieciom powyżej 2 lat i dorosłym. Do niedawna używana szczepionka polisacharydowa przeciwko meningokokom grupy A i C nie ma już praktycznie większego zastosowania ze względu na ograniczoną skuteczność[27].
Historia
Neisseria meningitidis po raz pierwszy opisał w 1887 roku Anton Weichselbaum[28].
Przypisy
- 1 2 3 Murray, Rosenthal i Pfaller 2011 ↓, s. 283.
- 1 2 3 4 5 Virella 2000 ↓, s. 142.
- 1 2 3 Cianciara i Juszczyk 2007 ↓, s. 665.
- ↑ Murray, Rosenthal i Pfaller 2011 ↓, s. 283-284.
- 1 2 3 4 Long, Prober i Fischer 2017 ↓, s. 748.
- 1 2 3 Murray, Rosenthal i Pfaller 2011 ↓, s. 285.
- ↑ Long, Prober i Fischer 2017 ↓, s. 749.
- 1 2 Murray, Rosenthal i Pfaller 2011 ↓, s. 284.
- 1 2 3 4 5 6 Cianciara i Juszczyk 2007 ↓, s. 666.
- ↑ Murray, Rosenthal i Pfaller 2011 ↓, s. 286.
- 1 2 G. Gabutti, A. Stefanati, P. Kuhdari. Epidemiology of Neisseria meningitidis infections: case distribution by age and relevance of carriage. „J Prev Med Hyg”. 56 (3), 2015. PMID: 26788731.
- 1 2 Cianciara i Juszczyk 2007 ↓, s. 664.
- 1 2 3 4 5 6 7 8 9 K. S. Brigham, T. J. Sandora. Neisseria meningitidis: epidemiology, treatment and prevention in adolescents. „Curr Opin Pediatr”. 21 (4), s. 437-443, 2009. DOI: 10.1097/MOP.0b013e32832c9668. PMID: 19421058.
- 1 2 3 4 Long, Prober i Fischer 2017 ↓, s. 753.
- ↑ Long, Prober i Fischer 2017 ↓, s. 752.
- 1 2 3 4 5 6 Cianciara i Juszczyk 2007 ↓, s. 667.
- ↑ Murray, Rosenthal i Pfaller 2011 ↓, s. 288.
- 1 2 Virella 2000 ↓, s. 141.
- 1 2 3 Murray, Rosenthal i Pfaller 2011 ↓, s. 289.
- ↑ Virella 2000 ↓, s. 144.
- 1 2 3 Cianciara i Juszczyk 2007 ↓, s. 668.
- ↑ Cianciara i Juszczyk 2007 ↓, s. 667-668.
- ↑ Cianciara i Juszczyk 2007 ↓, s. 669.
- 1 2 Andrzej Szczeklik, Piotr Gajewski: Interna Szczeklika 2014. Kraków: Medycyna Praktyczna, 2014, s. 2398-2399. ISBN 978-83-7430-405-4.
- ↑ PZH: Szczepionki przeciw zakażeniom meningokokowym. [dostęp 2017-07-15]. [zarchiwizowane z tego adresu].
- ↑ PZH: Szczepionki przeciw meningokokom w Programie Szczepień Ochronnych. [dostęp 2017-07-15]. [zarchiwizowane z tego adresu].
- ↑ Szczepienie przeciwko meningokokom pediatria.mp.pl [data aktualizacji: 12.09.2016]
- ↑ N. G. Rouphael, D. S. Stephens. Neisseria meningitidis: biology, microbiology, and epidemiology. „Methods Mol Biol”. 799, s. 1-20, 2012. DOI: 10.1007/978-1-61779-346-2_1. PMID: 21993636.
Bibliografia
- Janusz Cianciara, Jacek Juszczyk: Choroby zakaźne i pasożytnicze. Lublin: CZELEJ, 2007. ISBN 978-83-60608-34-0.
- Gabriel Virella: Mikrobiologia i choroby zakaźne. Elsevier Urban & Partner Wydawnictwo, 2000. ISBN 978-83-85842-59-0.
- Patric R. Murray, Ken S. Rosenthal, Michale A. Pfaller: Mikrobiologia. Wrocław: Elsevier Urban & Partner, 2011. ISBN 978-0-323-05470-6.
- Sarah S. Long, Charles G. Prober, Marc Fischer: Principles and Practice of Pediatric Infectious Diseases. Elsevier Health Sciences, 2017. ISBN 978-0-323-46132-0.
Przeczytaj ostrzeżenie dotyczące informacji medycznych i pokrewnych zamieszczonych w Wikipedii.
